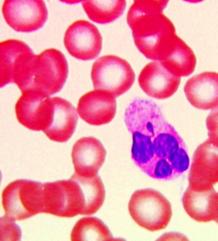

|
第二节 染色体
1848年,Hofmeister从鸭跖草的小孢子母细胞中发现染色体。
1888年,Waldeyer正式定名为Chromosome。
1879年,W. Flemming提出了染色质(chromatin)这一术语,用以描述染色后细胞核中强烈着色的细丝状物质。
后来的研究证明染色质和染色体是同一物质在不同细胞周期中的形态表现。
一、染色质的化学组成
染色质由DNA、组蛋白、非组蛋白及少量RNA组成,比例为1:1:(1-1.5):0.05。可见DNA与组蛋白的含量比较恒定,非组蛋白的含量变化较大,RNA含量最少。
(一)DNA
DNA是遗传信息的携带者,DNA的序列可分为3种类型,即:单一序列、中度重复序列(101-5)和高度重复序列(>105)。DNA的二级结构存在3种主要类型,即:B-DNA、Z-DNA、A-DNA(图12-9)。

图12-9
三种不同构象的DNA双螺旋
染色体具有3个基本元素(图12-10):①自主复制序列(autonomously replicating DNA sequence, ARS),是DNA复制的起点,酵母基因组含200-400个ARS,大多数具有一个11bp富含AT的一致序列(ARS consensus sequence, ACS);②着丝粒序列(centromere DNA sequence,CEN)
,由大量串联的重复序列组成,如α卫星DNA,其功能是参与形成着丝粒,使细胞分裂中染色体能够准确地分离;③端粒序列(telomere DNA sequence,TEL) ,不同生物的端粒序列都很相似,由长5-10bp的重复单位串联而成,人的重复序列为TTAGGG。

图12-10
染色体的三种基本序列
1983年,A. W. Murray等人首次成功构建了包括ARS、CEN、TEL和外源DNA,总长度为55kb的酵母人工染色体(yeast artificial chromosome, YAC)。YAC可用于转基因和构建基因文库,容纳插入片段的能力远高于质粒。
(二)组蛋白
组蛋白带正电荷,含精氨酸,赖氨酸,属碱性蛋白,其含量恒定,在真核细胞中组蛋白共有5种,分为两类:
一类是高度保守的核心组蛋白(core histone)包括H2A、H2B、H3、H4四种;另一类是可变的连接组蛋白(linker histone)即H1。
核心组蛋白的结构是非常保守,特别是H4,牛和豌豆H4的102个氨基酸中仅有2个不同,而进化上两者分岐的年代约3亿年历史。核心组蛋白高度保守的原因可能有两个:其一是核心组蛋白中绝大多数氨基酸都与DNA或其它组蛋白相互作用,可置换而不引起致命变异的氨基酸残基很少;其二是在所有的生物中与组蛋白相互作用的DNA磷酸二脂骨架都是一样的。
四种核心组蛋白均由球形部和尾部构成,球形部借精氨酸残基与磷酸二脂骨架间的静电作用使DNA分子缠绕在组蛋白核心周围,形成核小体。尾部则含有大量赖氨酸和精氨酸残基,为组蛋白翻译后进行修饰的部位,如乙酰化、甲基化、磷酸化等。
H1不仅具有属特异性,而且还有组织特异性,所以H1是多样性的。
(三)非组蛋白
与组蛋白不同,非组蛋白是染色体上与特异DNA序列结合的蛋白质,所以又称序列特异性DNA结合蛋白,非组蛋白的特性是:①含有较多的天门冬氨酸、谷氨酸,带负电荷,属酸性蛋白质;②整个细胞周期都进行合成,不象组蛋白只在S期合成,并与DNA复制同步进行;③能识别特异的DNA序列,识别信息存在于DNA本身,位点在大沟部分,识别与结合籍氢键和离子键。
非组蛋白的功能是:①帮助DNA分子折叠,以形成不同的结构域,从而有利于DNA的复制和基因的转录;②协助启动DNA复制;③控制基因转录,调节基因表达。
二、从DNA——到染色体
人体的一个细胞核中有23对染色体,每条染色体的DNA双螺旋若伸展开,平均长为5cm,核内全部DNA连结起来约1.7-2.0m,而细胞核直径不足10um。因此,不难想象DNA是以螺旋和折叠的方式压缩起来的,压缩比例高达上万倍,这种压缩的最初级结构就是核小体。
用非特异性核酸酶(如微球菌核酸酶)处理染色质,大多数情况下可得到大约200bp的片段,但处理裸露的DNA分子会得到随机降解的片段。以这个实验为基础,R. Kornberg建立了核小体模型。
核小体是一种串珠状结构,由核心颗粒和连结线DNA两部分组成,可描述如下(图12-11):①每个核小体单位包括约200bp的DNA、一个组蛋白核心和一个H1;②由H2A、H2B、H3、H4各两分子形成八聚体,构成核心颗粒;③DNA分子以左手螺旋缠绕在核心颗粒表面,每圈80bp,共1.75圈,约146bp,两端被H1锁合;④相邻核心颗粒之间为一段60bp的连接线DNA。

图12-11
核小体和螺线管的结构
通过核小体,DNA长度压缩了7倍,形成直径为11nm的纤维(图12-12)。但是染色质不以这种状态存在,在电镜下观察用温和方法分离的染色质是直径30nm的纤维,这种纤维的形成有两种解释:①由核小体螺旋化形成,每6个核小体绕一圈,构成外径30nm的中空管(图12-12),长度压缩6倍;②由核小体纤维Z字形折叠而成,长度压缩40倍。30nm纤维的形成与核小体之间蛋白质的相互作用有关,连接组蛋白H1和核心组蛋白尾部均参与这种相互作用,去除组蛋白H1的染色质中,30nm纤维解体为更细的纤维。

图12-12 30nm和11nm染色质纤维
对于更高级染色体包装方式,至今尚不明确。目前多认为30nm的纤维折叠为一系列的环(loop)结合在核骨架上(或称染色体骨架),结合点是富含AT的区域(图12-13),这种环状的结构散布于细胞核中。用盐溶液去除组蛋白,在电镜下可以看到,无论有丝分裂的染色体、灯刷染色体、间期的唾腺染色体上,都有大量的结合在骨架上的放射环,说明这种环并不是有丝分裂染色体所特有的。

图12-13
染色体的包装方式
三、异染色质和常染色质
间期核中染色质可分为异染色质(heterochromatin)和常染色质(euchromatin)。常染色质是进行活跃转录的部位,呈疏松的环状,电镜下表现为浅染(图12-14);易被核酸酶在一些敏感的位点(hypersensitive sites)降解。异染色质的特点是:在间期核中处于凝缩状态,无转录活性,也叫非活动染色质(inactive chromatin);是遗传惰性区;在细胞周期中表现为晚复制、早凝缩,即异固缩现象(heteropycnosis)。

图12-14
异染色质(核内深染部分)和常染色质(核内浅染部分)
结构(恒定)异染色质(constitutive heterochromatin):在所有细胞内和都呈异固缩的染色质,多定位于着丝粒区(图12-15),端粒,次缢痕及染色体臂的某些节段,在间期聚集成多个染色中心(chromocenter),由相对简单的高度重复序列构成。

图12-15
荧光原位杂交显示的着丝粒卫星DNA
兼性(功能)异染色质(facultative heterochromatin):是指不同细胞类型或不同发育时期出现的异染色质区。雌性哺乳类动物的X染色体就是一类特殊的兼性异染色质。在哺乳动物细胞内如有两个X染色体(通常为雌性),则其中的一个染色体常表现为异染色质(图12-16),称巴氏小体(barr body)。人的胚胎发育到16天以后,一条X染色体转变为巴氏小体,呈块状紧靠核膜,染色反应表现为深染。因此通过检查羊水中胚胎细胞的巴氏小体可预测胎儿的性别。
图12-16 白细胞中的巴氏小体(鼓槌状结构)
四、染色体结构
间期染色质分散于细胞核,但在分裂期,染色质通过盘旋折叠压缩近万倍,包装成大小不等、形态各异的短棒状染色体。中期染色体由于形态比较稳定是观察染色体形态和计数的最佳时期。
同一物种的染色体数目是相对稳定的,性细胞染色体为单倍体(haploid),用n表示,体细胞为2倍体(diploid)以2n表示,还有一些物种的染色体成倍增加成为4n、6n、8n等,称为多倍体。同一个体的体细胞并非都是2倍体,如大鼠肝细胞有4n、8n、16n等多倍体细胞,果蝇卵巢滋养细胞表现为2n、4n、8n、16n、32n、64n、128n等不同倍性,人类子宫内膜细胞的染色体数目变化在2n=17-103,为非整倍性。
染色体的数目因物种而异,如人类2n=46,黑猩猩2n=48,果蝇2n=8,家蚕2n=56,小麦2n=42,水稻2n=24,洋葱2n=16。在植物中染色体最少的是一种菊科植物Haplopapus gracillis 仅2对染色体,最多的是瓶尔草属phioglossum的一些物种,可达400-600对。在动物中染色体最少的是一种介壳虫的雄虫steatococcus tuberculatus仅有两条染色体,而另一极端是一种灰蝶有217-223对染色体。
(一)染色体形态和结构相关的术语(图12-17)

图12-17
染色体各部分的名称
1.染色单体(Chromatid):中期染色体由两条染色单体组成,两者在着丝粒的部位相互结合,每一条染色单体是由一条DNA双链经过螺旋和折叠而形成的,到后期,着丝粒分裂,两条染色单体分离。
2.染色线(Chromonema):前期或间期核内的染色质细线,代表一条染色单体。
3.染色粒(Chromomere):前期染色体上呈线性排列的念珠状颗粒,是DNA局部收缩形成的,异染色质的染色粒一般较大,而常染色粒的染色粒较小,在染色体上位于着丝粒两边的染色粒一般较大,而向染色体端部的染色体较小,呈梯度排列。
4.主缢痕(primary constriction):中期染色体上一个染色较浅而缢缩的部位,主缢痕处有着丝粒,所以亦称着丝粒区,由于这一区域染色线的螺旋化程序低,DNA含量少,所以染色很浅或不着色。一般动植物的染色体具有一个位置固定的着丝粒(localized contromere),有些生物整过染色体都具有着丝粒活性,称为全着丝粒(holocentromere)如:如蛔虫、线虫、蝶、蛾、蚜虫等。可根据着丝粒的位置将染色体分为4类:即①中着丝粒染色体(metacentric chromosome)。②亚中着丝粒染色体(submetacentric chromosome)。③亚湍着丝粒染色体(subtelocentric chromosome)和④端着丝粒染色体(telocentric chromosome)。划分的标准有:①臂比值r(长臂长/短臂长),②着丝粒指数i[(短臂长/染色体长)×100%],
③短臂长臂比等3种。
5.次缢痕(secondary constriction):除主缢痕外,染色体上第二个呈浅缢缩的部分称次缢痕,次缢痕的位置相对稳定,是鉴定染色体个别性的一个显著特征。
6.核仁组织区(nucleolar organizing regions, NORs):是核糖体RNA基因所在的区域(图12-18),其精细结构呈灯刷状。能够合成核糖体的28S、18S和5.8S rRNA。核仁组织区位于染色体的次缢痕区,但并非所有的次缢痕都是NORs。

图12-18
核仁组织者中心形成核仁
7.随体(satellite):指位于染色体末端的球形染色体节段,通过次缢痕区与染色体主体部分相连。位于染色体末端的随体称为端随体,位于两个次缢痕中间的称中间随体。
8.端粒(telomere):是染色体端部的特化部分(图12-19),其生物学作用在于维持染色体的稳定性。如果用X射线将染色体打断,不具端粒的染色体末端有粘性,会与其它片段相连或两端相连而成环状。端粒由高度重复的短序列串联而成,在进化上高度保守,不同生物的端粒序列都很相似,人的序列为TTAGGG。端粒起到细胞分裂计时器的作用,端粒核苷酸复制和基因DNA不同,每复制一次减少50-100bp,其复制要靠具有反转录酶性质的端粒酶(telomerase)来完成,正常体细胞缺乏此酶,故随细胞分裂而变短,细胞随之衰老。

图12-19 荧光原位杂交显示的端粒(上)和端粒序列(下)
(二)着丝粒的结构
着丝粒(centromere)和着丝点(kinetochore)是两个不同的概念,前者指中期染色单体相互联系在一起的特殊部位,后者指主缢痕处两个染色单体外侧表层部位的特殊结构,它与仿锤丝微管相接触。
着丝粒含3个结构域(图12-20),即:着丝点结构域(kinetochore domain)、中心结构域(central domain)和配对结构域(paring domain)。

图12-20
着丝粒的3个结构域
着丝点结构域(图12-21):位于着丝粒的表面,由外板(outer plate)、内板(inner plate)、中间区(interzone)和围绕外层的纤维冠(fibrous corona)。内外板的电子密度高,中间区电子密度低。内板与中央结构域的着丝粒异染色质结合,外板与微管纤维结合,纤维冠上结合有马达蛋白,如胞质Dynein和属于kinesin家族的CENP-E,为染色体的分离提供动力。

图12-21
着丝点结构域
中央结构域:位于着丝粒结构域的下方,含有高度重复的α卫星DNA构成的异染色质。
配对结构域:位于着丝粒结构的内层,中期两条染色单体在此处相互连结,在此区域发现有两类蛋白,一类为内着丝粒蛋白INCENP(inner centromere protein),另一类为染色单体连接蛋白CLIP(chromatid linking protein).
对着丝粒蛋白主要是使用ACA来研究的。ACA是从CREST 综合症病人血清中分离出来的抗着丝粒蛋白的抗体(anticentromere antibodies)。用ACAs发现鉴定出来的CENP主要有6种,即:CENP-A至F(表12-1)。
表12-1 几种着丝粒蛋白质的功能
|
类型 |
功能 |
|
CENP-A |
着丝粒特异性组蛋白 |
|
CENP-B |
与中央结构域的卫星DNA结合 |
|
CENP-C |
与着丝点结合 |
|
CENP-D |
与着丝点结合 |
|
CENP-E |
驱动蛋白类分子马达 |
|
CENP-F |
与着丝点结合 |
|
INCENP-A
|
连接姊妹染色单体 |
|
INCENP-B
|
连接姊妹染色单体 |
(三)核型与带型
早期对染色体的研究主要采用组织切片的方法,由于染色体经常不处于同一平面,因此很难对染色体进行观察和计数,以致于对人类到底有多少条染色体这样的问题一直争论到1956年才得以确认,这主要归功于50年代以后逐步发展起来的低渗处理,压片技术以及秋水仙来处理和细胞培养技术。二十世纪六十年代末至七十年代发展起来的各种染色体分带技术,使染色体的研究进入了一个黄金时代。为人类遗传病的鉴定,物种的血缘关系与进化研究、遗传育种等方面提供了重要的依据。
核型(karyotype)是细胞分裂中期染色体特征的总和,包括染色体的数目、大小和形态特征等方面。如果将成对的染色体按形状、大小依顺序排列起来叫核型图(karyogram, 图12-22),而染色体组型idiogram通常指核型的模式图,代表一个物种的模式特征。

图12-22
一种蝉(Platypleura kaempferi)的有丝分裂核型
染色体分带技术是经物理、化学因素处理后,再用染料对染色体进行分化染色,使其呈现特定的深浅不同带纹(band)的方法。分带技术可分为两大类,一类是产生的染色带分布在整过染色体的长度上如:G(图12-23)、Q(图12-24)和R带,另一类是局部性的显带,它只能使少数特定的区域显带,如C(图12-25)、Cd、T和N带。

图12-23
人类G带核型,G带显示的是染色体上富含AT的区域

图12-24
人类Q带核型,Q带显示的带纹与G带相似

图12-25
人类C带核型,C带显示的是着丝粒异染色质
(五)几类的特殊的染色体
1.多线染色体
1881年意大利的Balbiani发现于双翅目摇蚊幼虫的唾腺细胞。其特点是:①体积巨大(图12-26),比其它体细胞染色体长100-200倍,体积大1000-2000倍,这是由于核内有丝分裂的结果,即染色体多次复制而不分离。②多线性,每条多线染色体由500-4000条解旋的染色体合并在一起形成。③体细胞联会,同源染色体紧密配对,并合并成一个染色体。④横带纹,染色后呈现出明暗相间的带纹。⑤膨突和环,在幼虫发育的某个阶段,多线染色体的某些带区疏松膨大,形成膨突(puff),或巴氏环(Balbiani ring)。用H3-TdR处理细胞,发现膨突被标记,说明膨突是基因活跃转录的形态学标志。

图12-26
唾腺染色体
2.灯刷染色体
这种染色体最早发现于鱼类、两栖类和爬行类卵母细胞减数分裂的双线期。双线期是卵黄合成的旺盛期。由于染色体主轴两侧有侧环,状如灯刷,故名灯刷染色体(图12-27)。由两条同源染色体组成,在交叉处结合,每条同源染色体含2条染色单体。轴上有一些染色粒,代表染色质紧密螺旋化的部位。同时两条染色单体向两边伸出许多侧环,侧环是RNA活跃转录的区域。

图12-27
灯刷染色体
3.B染色体
1928年伦道夫(Randolph)把生物的正常染色体叫做A染色体,而把存在于许多动、植物中,形态和行为不同为A染色体的超数染色体称B染色体。 |